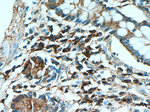
Human IgA Antibody in Immunohistochemistry (Paraffin) (IHC (P))

Search
Proteintech
Human IgA Monoclonal Antibody (3A5A5)
{{$productOrderCtrl.translations['antibody.pdp.commerceCard.promotion.promotions']}}
{{$productOrderCtrl.translations['antibody.pdp.commerceCard.promotion.viewpromo']}}
{{$productOrderCtrl.translations['antibody.pdp.commerceCard.promotion.promocode']}}: {{promo.promoCode}} {{promo.promoTitle}} {{promo.promoDescription}}. {{$productOrderCtrl.translations['antibody.pdp.commerceCard.promotion.learnmore']}}
产品信息
60099-1-IG
种属反应
宿主/亚型
分类
类型
克隆号
抗原
偶联物
形式
浓度
规格
纯化类型
保存液
内含物
保存条件
运输条件
产品详细信息
This antibody recognizes the Chain C region of human Ig alpha-1 (IGHA1).
Immunogen sequence: TSPKVFPLS LCSTQPDGNV VIACLVQGFF PQEPLSVTWS ESGQGVTARN FPPSQDASGD LYTTSSQLTL PATQCLAGKS VTCHVKHYTN PSQDVTVPCP VPSTPPTPSP STPPTPSPSC CHPRLSLHRP ALEDLLLGSE ANLTCTLTGL RDASGVTFTW TPSSGKSAVQ GPPERDLCGC YSVSSVLPGC AEPWNHGKTF TCTAAYPESK TPLTATLSKS GNTFRPEVHL LPPPSEELAL NELVTLTCLA RGFSPKDVLV RWLQGSQELP REKYLTWASR QEPSQGTTTF AVTSILRVAA EDWKKGDTFS CMVGHEALPL AFTQKTIDRL AGKPTHVNVS VVMAEVDGTC Y (4-353 aa encoded by BC016369)
靶标信息
Human IgA, also known as human immunoglobulin A, is an antibody that is produced by the immune system in response to antigens. It is the most abundant immunoglobulin in mucosal secretions, such as saliva, tears, and breast milk, and plays a key role in defense against pathogens at mucosal surfaces. IgA works by binding to specific antigens and preventing them from entering the body's tissues. It can also activate complement and promote phagocytosis by immune cells. Human IgA can be used in research to study the immune response to pathogens and to develop diagnostic tests and therapeutic interventions for infectious diseases.
仅用于科研。不用于诊断过程。未经明确授权不得转售。
生物信息学
蛋白别名: A2m Marker; Ig alpha 1 Chain C Region; Ig alpha 2 Chain C Region; IgA1; Immunoglobulin A; Immunoglobulin Am1; Immunoglobulin Am2; Immunoglobulin Heavy Constant Alpha 2; unnamed protein product
基因别名: A2M; IgA1
Entrez Gene ID: (Human) 3493, (Human) 3494